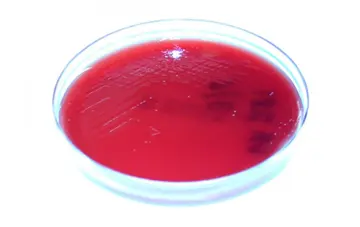

این آزمایش جهت تشخیص عفونت ویروسی هپاتیت صورت می پذیرد.
آزمایشگاه - صفحه 2
تست های عملکرد کبد آزمایش های خونی هستند که برای کمک به تشخیص و پایش بیماری ها یا آسیب های کبدی استفاده می شوند. این آزمایشات سطوح آنزیم ها و پروتئین های خاصی را در بدن شما اندازه گیری می کنند.
333
آزمایش منظم خون یکی از مهمترین و اساسیترین گامها برای پیگیری و کنترل سلامت عمومی بدن است.
شماره ۱۲۱۹
یکیاز نگرانیهای عمده در دورانبارداری، بیاطلاعی از وضعیت سلامتجنین درحین دوره ۹ماهه بارداری میباشد که به کمک مراقبتهای دورانبارداری و انجام تستهای موردنیاز، این نگرانیها بهحداقل رسیده است. ازجمله برای بررسی وضعیت جنین ازنظر ابتلابه ناهنجاریهای کروموزومی تستهایی وجود دارد که در ۳ماهه اول و دوم بارداری انجاممیشود و خطر ابتلای جنین به اینگونه ناهنجاریها را مشخصمیکند که البته ماهیت تستها در سهماهه اول بارداری متفاوت از تستهایی است که در دوران ۳ماهه دوم بارداری انجاممیشود و تحتعنوان Triple Test میباشد. این مقاله به بررسی تست تریپل میپردازد.
شماره ۱۱۶۵
طبق تحقیق ارائهشده در بیستوهفتمین کنگرهاروپایی میکروبشناسی بالینی و بیماریهای عفونی(2017,ECCMI)، آزمایش روی نشانگرهای مولکولی در ادرار بیماران پیوند کلیه شده، میتواند شکست پیوند کلیه و دلیل آن را آشکار نماید.
شماره ۱۱۶۴
322
علاوهبراین ، ۹۴ درصد از نتایج این آزمایشخون درعرض ۷۲ ساعت پساز گرفتن نمونههای خون مهیا شد که بهطور قابلتوجهی سریعتر از نتایج حاصل از بیوپسیهای بافتی میباشد.
شماره ۱۱۴۹
شماره ۱۱۶۱
بیماری کبدچرب غیرالکلی(NAFLD) میلیونها تَن از مردم آمریکا را تحتتأثیر قرارداده است. این بیماری اغلب تا زمانیکه بهخوبی پیشرفتکرده باشد، تشخیصداده نمیشود و تشخیص قطعی به بیوپسیکبد نیاز دارد.
شماره ۱۱۴۹